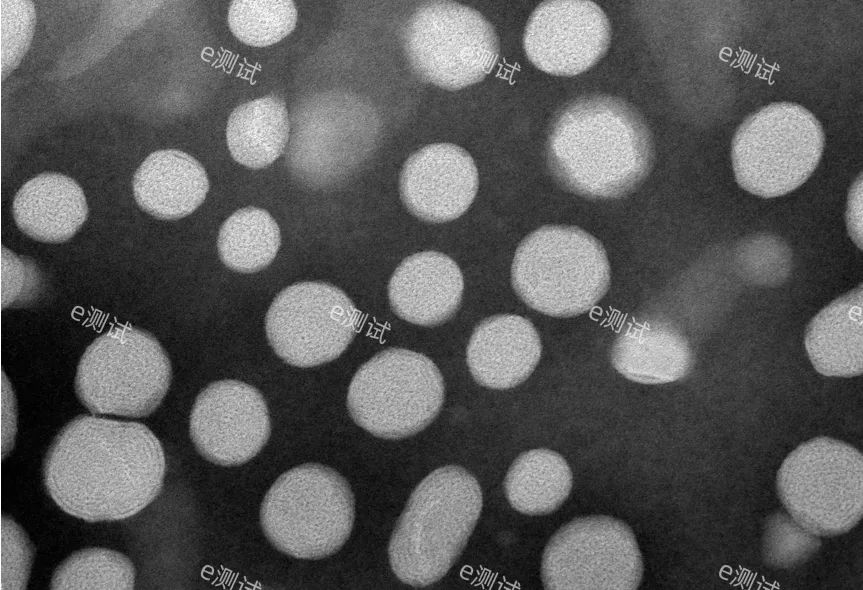
4ada63304d6d17500ac39b570ab225a2.jpg
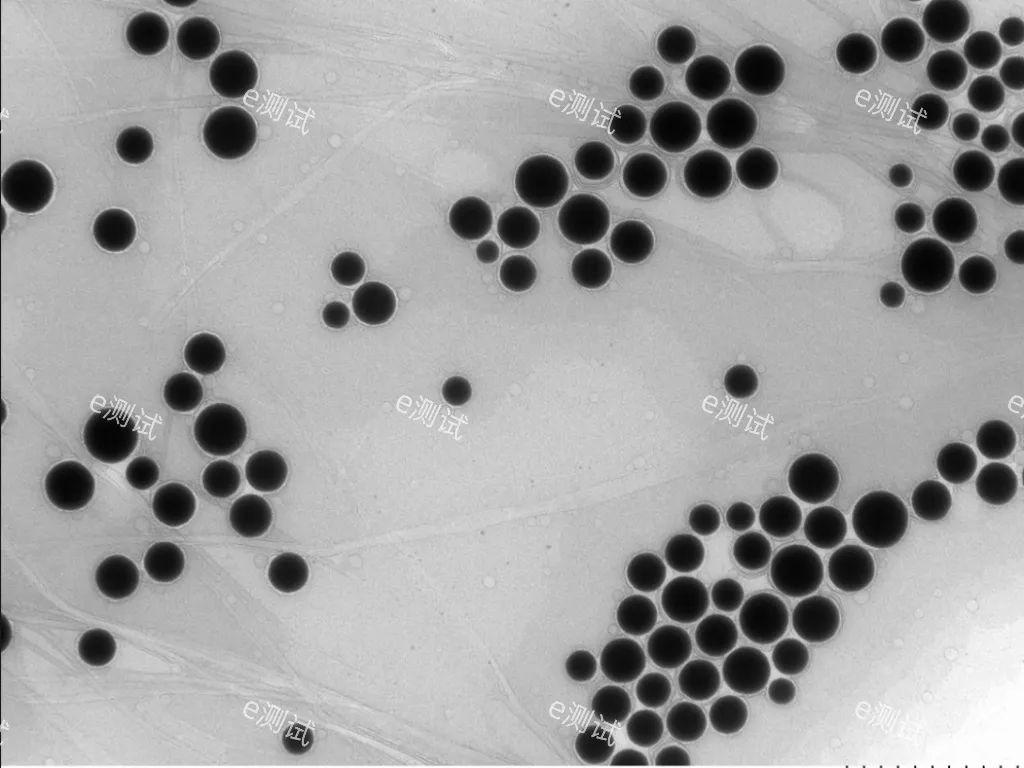
ba63f708138076356b1e9bb33869cbaa.jpg

负染色技术是一种制备电子显微镜样品图像呈现复反差的技术。用于观察样品中的颗粒性物质或生物大分子。用金属盐对铺展在载网上的样品进行染色,使整个载网都铺上一层重金属盐,而有凸出颗粒的地方则没有染料沉积。染色后,在电镜下观察时,被观察的对象为亮的,背景为暗的。负染色是只染背景而不染样品,与光学显微镜样品的染色正好相反。目前最常用的负染液是醋酸铀或者磷钨酸。
生物干货| 透射电镜之负染色技术
2024-05-27 17:08:57 2 4427
一、什么是负染色技术

样本类型:一般负染的样品包括蛋白质、脂质体、外泌体、细菌、病毒及各种有机聚合物纳米材料。
特点:不需经过固定、脱水、包埋和超薄切片等复杂操作,而是直接对沉降的样品匀浆悬浮液进行染色。
优点:操作简便、用量极少、省时快速及分辨力高。
二、制样步骤
常用的负染制样方法有混合法、悬滴法、漂浮法等,本实验室常用的是悬滴制样法,具体制样流程如下:

1、样品准备:首先,将稀释后的生物样品滴在载网上,通常是涂布在一个网格状的铜或镍网上的小洞(也称井)内。
2、负染色剂添加:随后迅速滴加一种高电子密度的染色剂,如磷钨酸、醋酸铀等。这些染料对电子束有很强的散射作用,在TEM下显示出明显的暗色背景。
3、吸附与干燥:染色剂溶液围绕并渗透进入样品内部,但不与样品发生化学反应,而是通过物理吸附形成一层包裹样品的高密度外壳。然后样品经过自然挥发或加速干燥,使染色剂固定在样品周围及可能的部分内部空隙中。
4、电镜观察:在透射电镜下观察时,由于高电子密度的染色剂形成的背景区域对电子的吸收或散射能力较强,因此在图像上呈现为暗色;而样品因其较低的电子密度相对显得较为透明或亮色,从而与暗色背景形成鲜明对比,使得样品的轮廓和形态特征得以清晰显现。
三、样本要求
1.样本量及寄送要求:
(1)液体样品提供至少100μl,并配置好合适的浓度(上机前直接滴加样品,不做稀释或浓缩),浓度、纯度对拍摄效果影响比较大;
(2)粉末样品30mg左右,并注明溶剂类型及配置比例;
(3)外泌体样品100μL,干冰运输寄送(不少于10kg干冰);
(4)病毒(灭活)、细菌样本,4℃运输寄送;
2.样品注意运输方式,需要冰袋或者干冰运输的请提前说明,并附详细送检要求的预约单。
3.测试周期:一般为样品接收后的1周左右,如遇法定假期需要顺延,具体实验周期及送样时间请与e测试工作人员沟通确认,谢谢!
4.交付数据:每样提供8张拍摄图片(不提供分析服务)。如需更多照片请提前与e测试工作人员沟通确认,并且会产生额外费用,请悉知!结果反馈请在测试完成一周内,不建议回收样品,如有需要请提前反馈给e测试工作人员。
负染色的效果可能与样本的运输时间、浓度、纯度有关,如需负染色,关于样本准备和测试安排,请提前与e测试工作人员沟通确认。
四、结果展示
01

外泌液
02
蛋白
03
纳米乳液
04
病毒颗粒
五、常见问题
1、透射电镜正染色和负染色的区别?
负染色又称阴染色,是相对于普通染色(称正染色)而言。所谓负染,是指通过重金属盐加强样品外周的电子密度,使样品显示负的反差,衬托出样品的形态和大小。
在超薄切片的染色中,染色后的样品结构的电子密度因染色而被加强,在图像中呈现黑色,而背景因未被染色而呈光亮,这种染色称为正染色。而在负染色中则相反,由于染液中某些电子密度高的物质(如重金属盐等)“包埋”低电子密度的样品,结果在图像中背景是黑暗的,而样品像“透明”的光亮,两着之间的反差正好相反,故称为负染色。
2、染液如何进行选择?
① 磷钨酸,一般用双蒸水配制成10-30g/L的溶液(pH6.4-7.0),常用于病毒、细菌、纳米聚合物等样品染色。
② 醋酸双氧铀,通常用双蒸水制成2-20g/L的溶液(pH可不调),常用于蛋白质样品、细胞外囊泡、脂质体等样品染色。
③ 甲酸铀,配置成5-20g/L的溶液(pH3.5),常用于蛋白质染色。
3、载网如何进行选择?
一般选用300目/400目有膜的载网。
①载网在使用时需要注意哪一面是有膜面,如果肉眼无法辨别,建议在光镜下辨认。
②碳膜载网通常亲水性稍差,建议使用前进行亲水处理(离子溅射仪、紫外光照射、加0.05%BSA等)。
本文为e测试原创,未经允许,禁止转载!
推荐文章
-
2021-09-02 0 5434
-
2020-10-21 30 3585
-
2021-06-22 0 3020
-
2024-07-04 0 2655
-
2024-07-04 0 2534